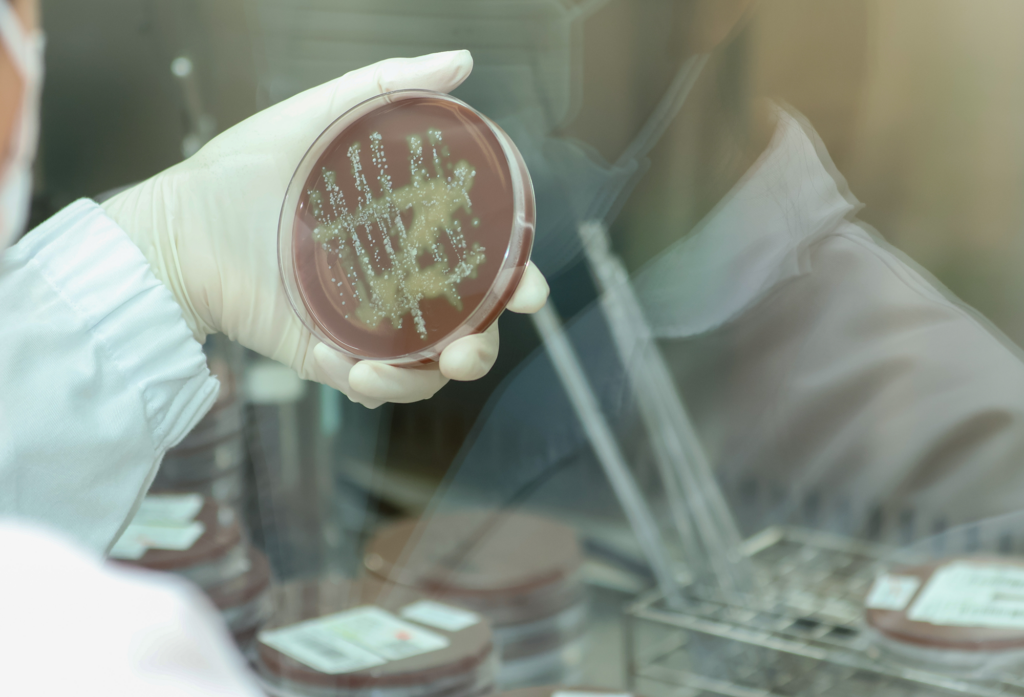

Disseny i construcció de soques microbianes
Aquest servei es centra en el disseny in silico (computational assisted design, CAD) de soques microbianes utilitzant un ventall d’eines i metodologies de modelització, en la seva construcció fent ús d’un conjunt d’eines de biologia sintètica, i en la verificació i comparació experimental del fenotip de les soques resultants a petita Escala (plataforma de selecció/prova de soques en paral·lel, és a dir, a escala plaques de pous o Erlenmeyers).
Caracterització de soques microbianes
Aquest servei es centra en la caracterització de soques microbianes a escala bioreactor, concretament en la determinació de paràmetres estequiomètrics i cinètics (rendiments, velocitats específiques i productivitats), preferiblement en mode discontinu i continu. Es fa ús d’eines de monitoratge en línia dels gasos de sortida (OUR, CER i RQ), i reconciliació de dades. Si es requereix, també es poden obtenir mostres per a estudis posteriors mitjançant tècniques òmiques (transcriptòmica, proteòmica, metabolòmica, fluxòmica basada en tècniques de marcatge amb 13C).


Desenvolupament de processos microbians
En aquest servei s’apliquen estratègies d’enginyeria de bioprocés per a desenvolupar de manera integrada la bioproducció de productes recombinants (proteïnes, compostos químics/metabòlits d’interès) en factories cel·lulars microbianes (bacteris i llevats), incloent el procés de fermentació i les etapes primàries de recuperació. En base a les dades generades en els cultius en discontinu i continu, es dissenya I s’implementa l’operació de cultius en discontinu alimentat (fed-batch) a elevades densitats cel·lulars, fins a bioreactor d’escala 5 L.
Immobilització de biocatalitzadors
Aquest servei té com a objectiu desenvolupar un procés d’immobilització de biocatalitzadors. Es provaran diversos suports amb diferents matrius i grups funcionals per avaluar el rendiment de la immobilització, l’activitat retinguda i l’activitat recuperada. L’estabilitat derivada immobilitzada també es podria provar en condicions d’emmagatzematge.


Escalat de bioprocessos (microbians i biocatalítics)
Aquest mòdul pretén adaptar els procediments i metodologies desenvolupats a escala de laboratori fins a escala de preproducció. Això permet a l’usuari avaluar la viabilitat tècnica i econòmica del procés, així com les quantitats de producte fent possible valorar la seva aplicabilitat i comportament. L’objectiu del servei és transferir i verificar com es poden implementar els protocols i mètodes que s’han determinat a escala laboratori (bench scale, 1-2 L) fins a escales superiors (10-50 L).
Producció per contracte a escala pilot
Un cop desenvolupat un protocol de producció a escala pilot (50 L), s’ofereix la possibilitat de realitzar processos productius sota contracte. L’objectiu és disposar de quantitats de producte definides per l’usuari que permetin realitzar els passos posteriors del procés de validació del producte, ja sigui per a estudis de mercat o per a la realització de proves en diferents aplicacions, etc.


Consultoria científica tècnica
Proporcionar informació i coneixement per resoldre les necessitats científiques i tecnològiques dels diferents grups d’interès, incloent l’elaboració d’estudis (per exemple, sobre l’estat de l’art d’una determinada tecnologia o domini científic, suport en l’elaboració de procediments, processos i metodologies), activitats de consultoria i de transferència de coneixements teòrics i/o pràctics a sector empresa (per exemple, a través de cursos de capacitació dissenyats a mida), des de start-ups a grans empreses.